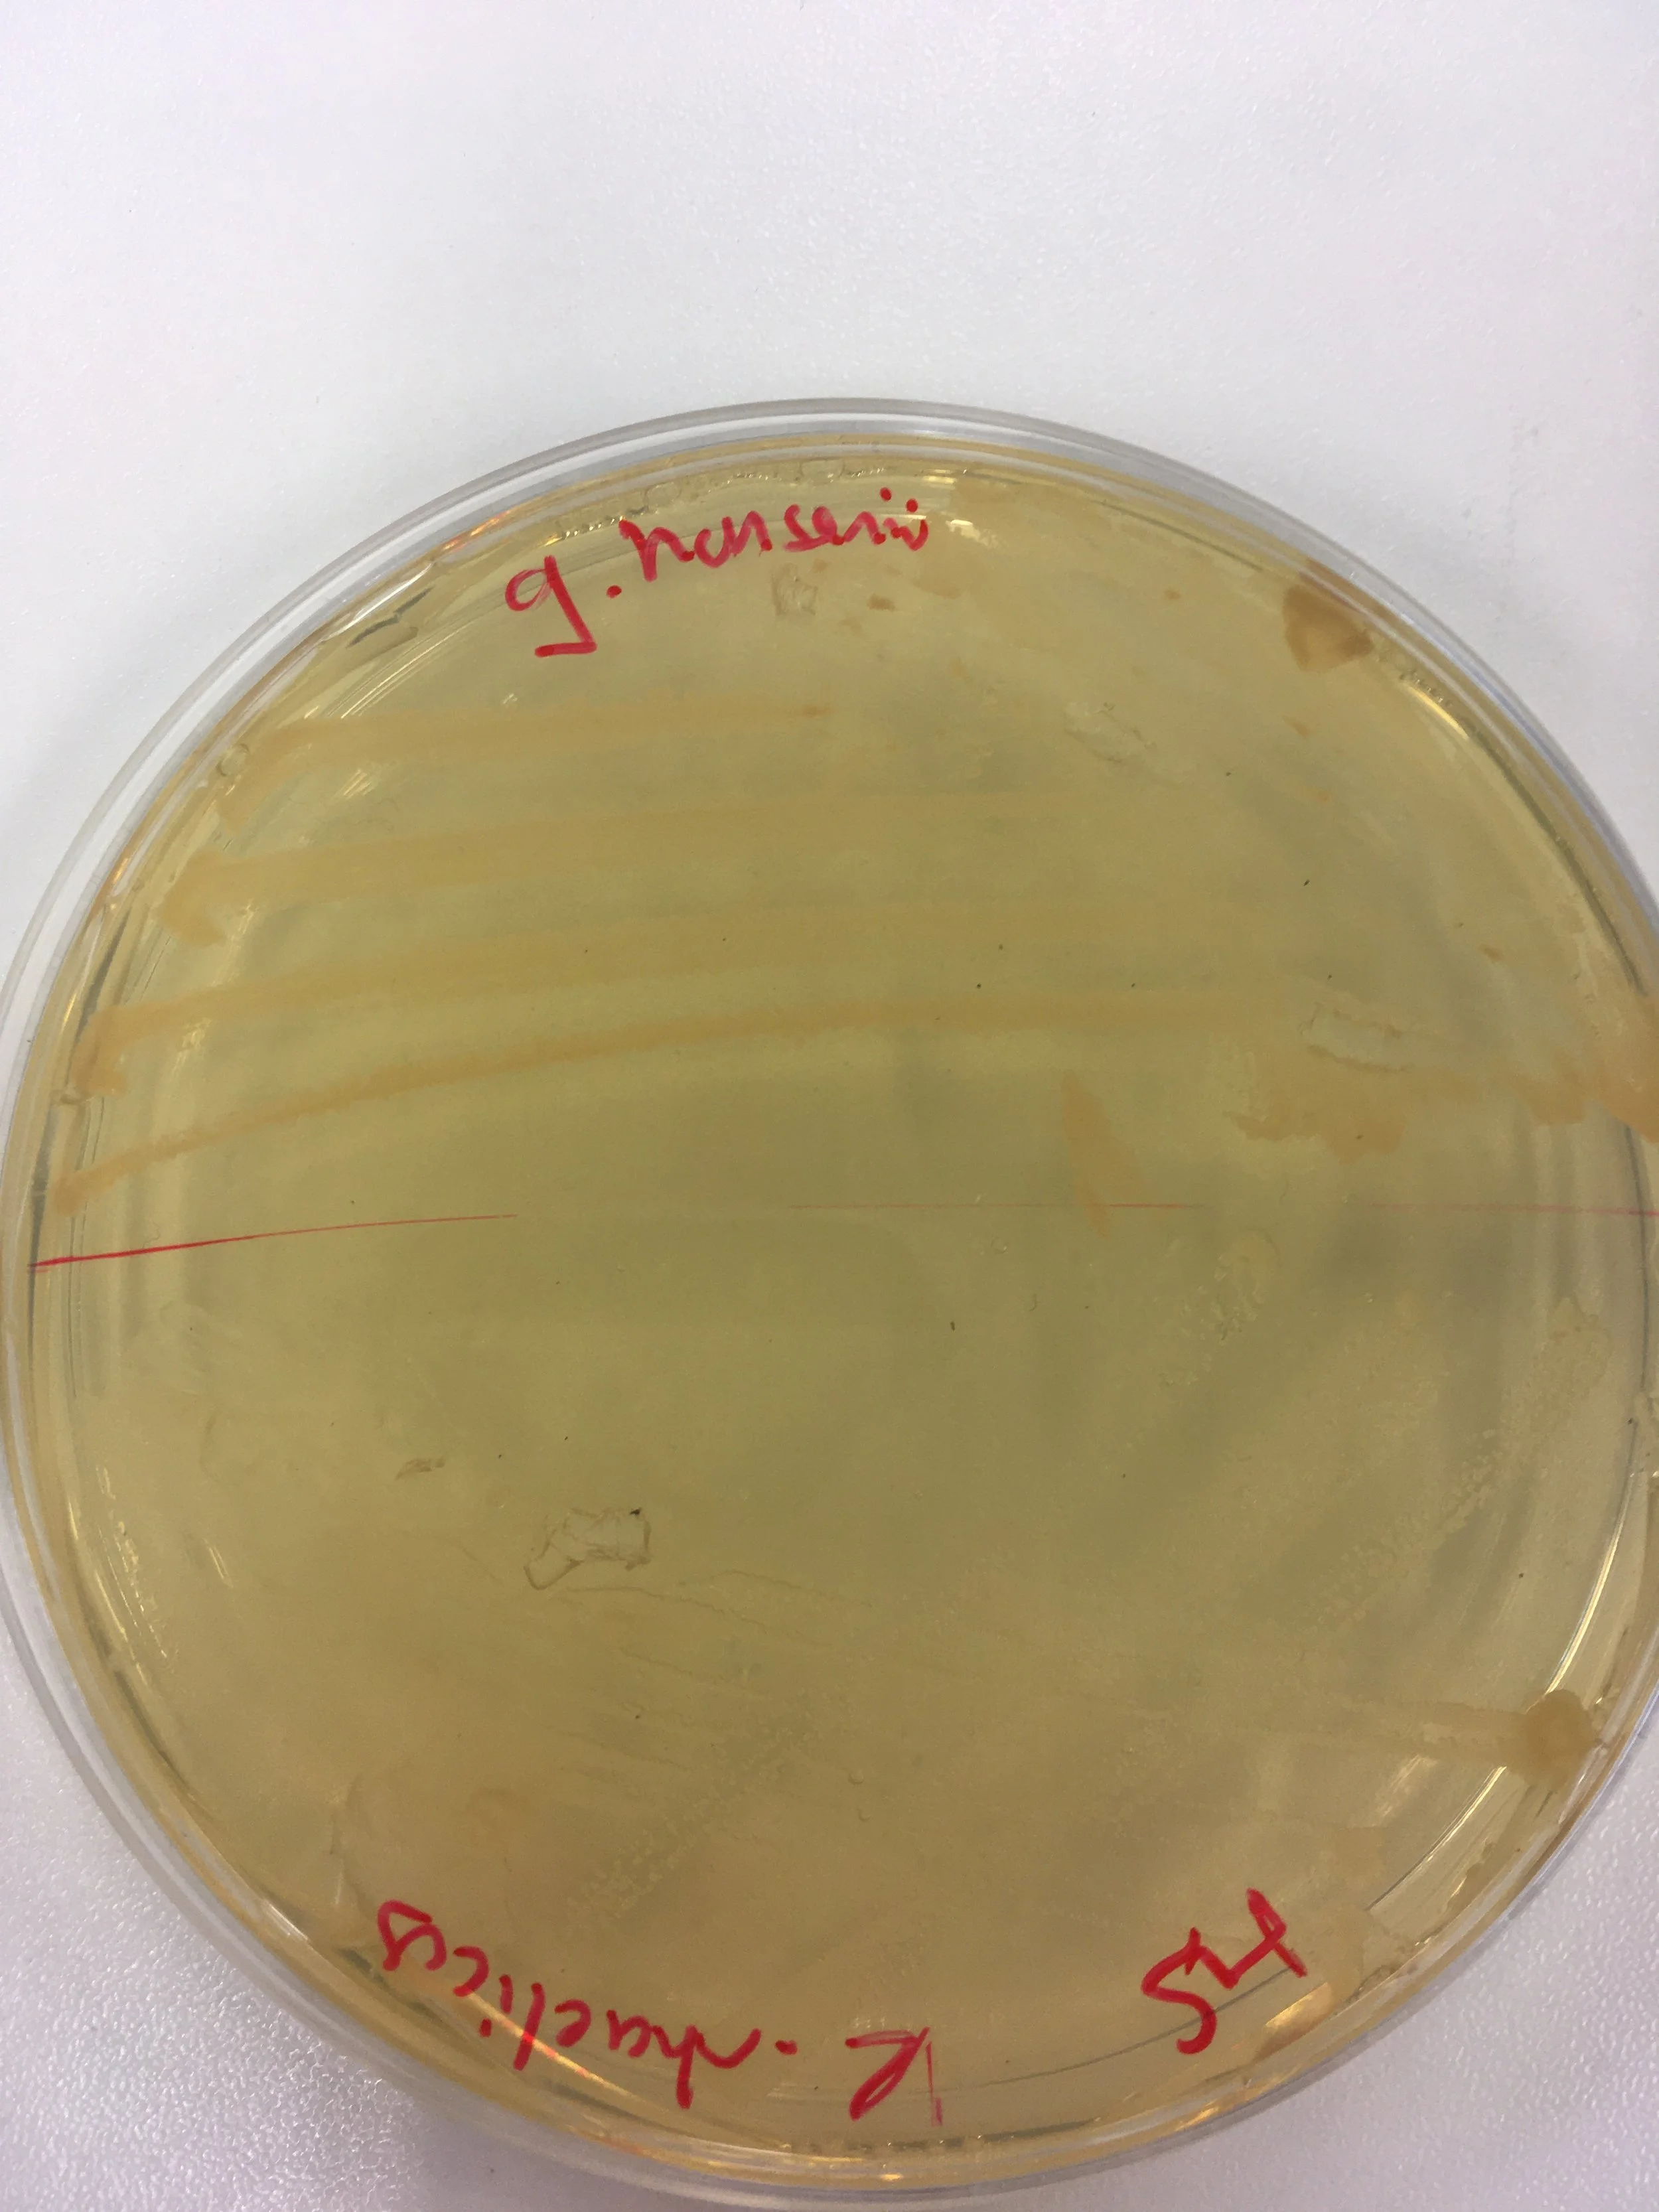

Interdisciplinary Designer and Researcher
Pg Cert Psychedelics: Mind, Medicine and Culture University of Exeter
MA Material Futures Central Saint Martins UAL
BA Fashion Design Central Saint Martins UAL
Exploring the entanglement of human and planetary health through the lens of psychedelic research. Speculative and critical design with a regenerative, living systems approach. One Health advocate. Designing artefacts, therapeutic processes and experiences mediated through symbiotic social and material relations. Considering material innovation, ‘ancestral futures’ and new animism to extend the definition of stakeholders in scientific research to include our ‘more than human’ ‘communitas’.
Nature-Centric Approach ASRA-United Nations Foundation “Becoming River”
Designed and prototyped an interactive 3D river ecosystem game in Unity with conceptual potential for ArcGIS integration in 3 weeks, applying the ASRA systemic risk assessment framework to model cascading environmental risks and intervention pathways. Developed a prototype demonstrating how multi-perspective visualisation (willow tree, beaver, salmon, dragonfly) can communicate complex interconnected ecological risks to policymakers and research communities.
Therapeutic Settings and Ecology
Therapeutic Settings and Ecology
DESIGN WORK
Plan(e)t Medicine
The Material Futures Central Saint Martins speculative, design thesis investigates the interconnectedness of human and planetary health. Central to the project is an interactive vending machine, which utilises a neural language model developed through the analysis of over 100 research papers on psychedelics and nature connectedness. Users engage with an interactive game and ‘therapist’ and based on their responses, are prescribed a speculative bacterial cellulose psilocybin micro-patch, a nature prescription and an accompanying soundtrack. This design critically examines and explores the potential applications of artificial intelligence in medical research and critiques the capitalist, hyper medicalisation of psychedelics. Won Honouree Psychedelic Design Award 2025.









Featured in exhibition “Human Resources” at Letheby Gallery for London Design Festival
An environmentally responsible exhibition provoking the question of what happens when we start to move to inner (human) resources. The exhibition provoked the question; What happens when we expand our definition of what a resource might be – when we move from practices of extraction and acquisition to drawing on our own inner resources?

Me, Myself, AI
Visualising data through machine learning. Quantitatively analysed psychedelic research papers to understand the power dynamics of scientific knowledge production and what voices are dominating the discourse. This was visually represented through different coloured pixels. The print was featured in the Harvard Psychedelic Art show 2024.


Trans-Spiritual
‘Making Waves’ a trans-disciplinary project between UAL, Queen Marys and Tokyo Institute to bridge the gap between research and its dissemination and how applying critical design and systems thinking can inform and transform scientific inquiry. Methods of micro-phenomenology were used to model pre-reflective experience for knowledge sharing and to build a framework for understanding the environmental crisis and its relation to the psyche. Observing Physarum polycephalum, we explored the embodiment of the non-human. Developing an audio ‘Trans-Spiritual’ from the frequency of slime mould we co-created a therapeutic, sensorial, healing space aiming to understand whether given the same environmental conditions; humans would mimic or replicate reciprocals way of being.
Healing BioMaterials
Can design raise collective consciousness? A speculative design proposition exploring the emotional healing properties of materials.
The proposal was to develop a Bacterial Cellulose micro patch engineered with micro needles and encapsulated with Ashwagandha to explore the potential of living materials in topical drug delivery.

Wey A(y)lgae
Cultivating a harmonious atmosphere for algae biomass to grow exponentially through the use of music. Based on research of Freeman et al., (2019). The soundscape was recorded using a kelp horn, harnessing nostalgic ‘fantasound’ of Walt Disneys score of the Little Mermaid and recorded at the frequencies 432hz (Water), 256hz (Chlorophyll) and 384hz (Oxygen) to understand how algae interrelates acoustically. An Algae biomaterial was developed as an alternative to Vinyl.

Brain Waves
Participated as a creative consultant to Brain Waves 2023 project at Dolby Studios. EEG brain recordings were taken whilst listening to Pink Floyds ‘Great Gig in the Sky’ to understand the emotional response to music. This was translated into art work.
NOW PLAY THIS
NOW PLAY THIS
Participatory game design for Somerset House Design Festival ‘Now Play This’ around the the theme of democracy. Legislative theatre as a methodology was utilised to understand flow states. The interactive fiction game ‘Forest Journey’ emerged as a meditative, reflective game. With the forest as the earths lungs, grounding and breathing techniques are included throughout the game acknowledging nature has a voice in the democratic process. Affirmation: In natures playground I allow myself joy and the opportunity to play.




Psychedelic Visuals and Digital Therapeutic tools for Psychedelic Integration coming soon….
Fashion Assistant Styling Dazed and Confused
Fashion Assistant Styling Dazed and Confused



Made for Anselm Kiefers exhibition at White Cube gallery, Alkahest, a stream of lead-fringed photographs of changing light on a beach spilling from a heavily oxidised lead bucket, refers to the exhibition’s title theme – The Mystery of the Cathedrals – taken from a 1926 treatise by esoteric writer Fulcanelli, claiming that the secrets of alchemy are revealed in the structures of medieval cathedrals.
Artist Assistant Anselm Kiefer White Cube Gallery
Artist Assistant Anselm Kiefer White Cube Gallery



Material and Knitwear Design




















